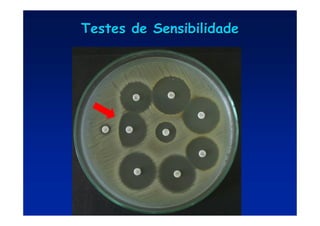
Testes de Sensibilidade
Testes de Sensibilidade
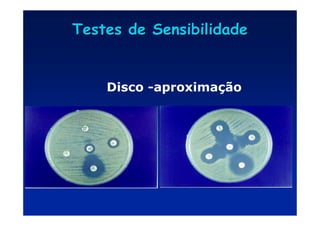
Testes de Sensibilidade
Testes de Sensibilidade
Disco -aproximação
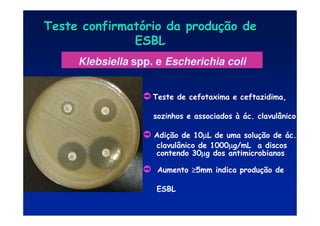
Klebsiella spp. e Escherichia coli
· Teste de cefotaxima e ceftazidima,
sozinhos e associados à ác. clavulânico
· Adição de 10µ
µ
µ
µL de uma solução de ác.
clavulânico de 1000µ
µ
µ
µg/mL a discos
contendo 30µ
µ
µ
µg dos antimicrobianos
· Aumento ≥
≥
≥
≥5mm indica produção de
ESBL
Teste confirmat
Teste confirmató
ório da produ
rio da produç
ção de
ão de
ESBL
ESBL
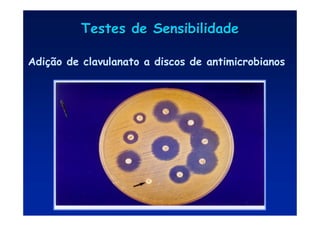
Adição de clavulanato a discos de antimicrobianos
Testes de Sensibilidade
Testes de Sensibilidade

O documento discute os mecanismos de ação e resistência aos antibióticos. Apresenta as principais vias de ação dos antibióticos, incluindo inibição da síntese da parede celular, da membrana celular, de proteínas e ácidos nucleicos. Também descreve os mecanismos de resistência bacteriana, como modificação do alvo, redução da permeabilidade e efluxo aumentado, inativação enzimática do antibiótico. A resistência pode ser intrínseca ou adquirida através da aquisição de genes.

![S. aureus
Penicilina
[1950s]
Penicilina-resistente
S. aureus
Evolução da resistência microbiana do S. aureus
Meticilina
[1970s]
Oxacilina-
resistente
S. aureus (MRSA)
Enterococo resistente
À vancomicina (VRE)
Vancomicina
[1990s]
[1997]
Vancomicina
Resistência
intermediária
S. aureus
(VISA)
[ 2002 ]
Vancomicina
resistente
S. aureus
12 Steps to Prevent Antimicrobial Resistance: Hospitalized Adults
Step 9: Know when to say “no” to vanco](https://image.slidesharecdn.com/comoescolherantibioticos-210323160144/85/Como-escolher-antibioticos-109-320.jpg)










